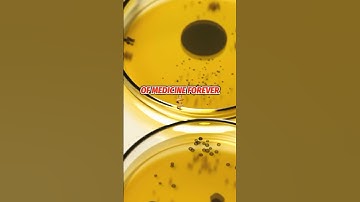
Science is Awesome! Bacteria-killing mold. 🍄

⬇ DOWNLOAD NOW
Jika muncul iklan pop-up, tutup lalu klik tombol kembali
Download lagu One of the popular science of mold tuning knowledge secara gratis hanya untuk keperluan promosi. Dukung artis favorit kamu dengan membeli musik original di iTunes atau platform resmi lainnya.
 The third popular science of mold tuning knowledge
The third popular science of mold tuning knowledge How Mold Made Medicine History
How Mold Made Medicine History Salt-water Versus bacteria under the Microscope!
Salt-water Versus bacteria under the Microscope! This is one of the weirdest reactions I've ever seen
This is one of the weirdest reactions I've ever seen Science is Awesome! Bacteria-killing mold. 🍄
Science is Awesome! Bacteria-killing mold. 🍄 Cell Explodes Under Microscope (Hydrogen Peroxide vs Germs)
Cell Explodes Under Microscope (Hydrogen Peroxide vs Germs) Scientists Finally Know How Roman Concrete Was Made
Scientists Finally Know How Roman Concrete Was Made Bacteria VS Tequila alcohol under the microscope!
Bacteria VS Tequila alcohol under the microscope!